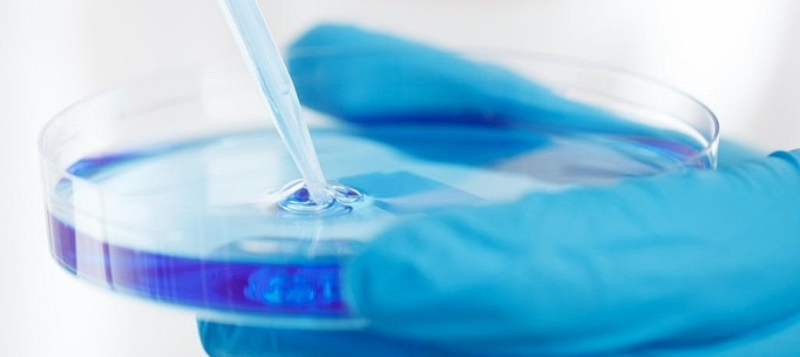
pipet800x357

About us
The Eurofins Agro global network provides all relevant testing for agricultural, nature and landscape management with innovative soil, plant, food, feed, fertiliser, water, manure and waste analysis.

What characterises us


System approach
Eurofins Agro embraces the system approach, acknowleding the inter-relationships and interdepency of the components of the agri-food system.
Better insights
Analysing all components helps identify factors that may influence and modify the agri-food system.
Tools for sustainability
We believe that providing tools for the system approach contributes to improving crop productivity and quality, and to nutritional security and environmental sustainability.
Supporting farmers and growers
We help farmers and growers to operate their business in a healthy, viable and sustainable way.
Enabling food companies
Food and feed companies can prove sustainable production with our reliable data.
Guiding governments and research
Governments and researchers use our tools for achieving their goals, such as Sustainable Development Goals.
Eurofins Agro Competence Centre

Global research
The Eurofins Agro Competence Centre is the global research and innovation organisation of Eurofins Agro worldwide.
Scientific backbone
It is the scientific backbone of the 600.000 annual analyses of soil, plant, food, feed, fertiliser, water, manures and wastes. We work together with several agricultural universities in Europe.
Powered by history
With nearly 100 years of experience, the Competence Centre in Wageningen, the Netherlands, has been a trusted authority in soil, crop and horticultural analysis since its establishment in 1927.

Our worldwide network "Agro Laboratory as a Service"

Global NIRS network
aLaaS connects labs worldwide to standardise agricultural analysis.
Consistent results
Every lab delivers identical results, anywhere in the world.
Guaranteed quality
All procedures meet Eurofins Agro’s high standards for reliability.
About the worldwide NIRS network of Eurofins Agro for analysis of roughages, feeds, raw materials, TMRs and soil.

How we help
Sampling, analysis and advice

Find a site near you!





















